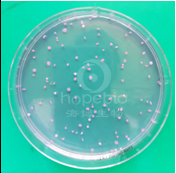

海博微信公众号
海博天猫旗舰店




本培养基用于霉菌和酵母菌的计数。
蛋白胨在培养基中作为基础营养物质提供菌体生长所需的氮源和氨基酸,葡萄糖提供碳源,磷酸二氢钾是缓冲剂,玫瑰红钠是一种指示剂并能抑制霉菌菌落生长过大而漫延,琼脂是凝固剂。
二、培养基配方(g/L):
|
蛋白胨 |
5.0 |
|
磷酸二氢钾 |
1.0 |
|
玫瑰红钠 |
0.0133 |
|
硫酸镁 |
0.5 |
|
葡萄糖 |
10.0 |
|
琼脂 |
14.0 |
|
pH 6.0±0.2 25℃ |
|
三、试验方法:
称取本品干粉31.5g,加入1000mL蒸馏水,121℃高压灭菌15分钟备用。
四、结果观察与解释:
接种以下质控菌株,放置20-25℃需氧培养48-72小时。
|
质控菌株 |
菌株编号 |
接种量(CFU) |
对照培养基 |
回收率 |
生长情况 |
其它特征 |
|
酵母菌 |
ATCC 9763 |
50-100 |
SDA |
≥70% |
+++ |
粉红色菌落 |
|
白色念珠菌 |
CMCC 98001 |
50-100 |
SDA |
≥70% |
+++ |
粉红色菌落 |
|
黑曲霉 |
CMCC 98003 |
50-100 |
SDA |
≥70% |
+++ |
有黑色孢子 |

a b c
图1玫瑰红钠琼脂培养基微生物质控结果
备注:a:酵母菌,b:白色念珠菌,c:黑曲霉
五、注意事项
倾注培养基的温度过高会损伤或烫死样品中的微生物而影响计数,一般倾注温度要求在45℃左右为宜。
相关产品:
注:本文属海博生物原创,未经允许不得转载。
上一篇:亮绿乳糖培养基原理及实验现象
